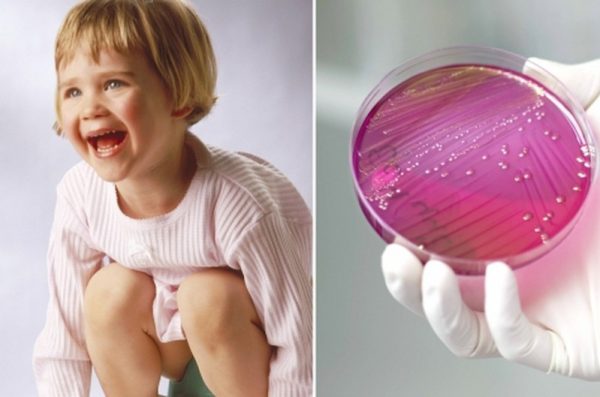

Инфекция мочевыводящих путей у детей: причины, симптомы и методы лечения
Инфекции мочевыводящих путей у детей случаются сплошь и рядом. Но в силу отсутствия очевидных симптомов, родители часто невольно запускают развитие болезни. Как правильно диагностировать ИМВП у ребенка и чем лечить эту инфекцию — расскажем подробно!